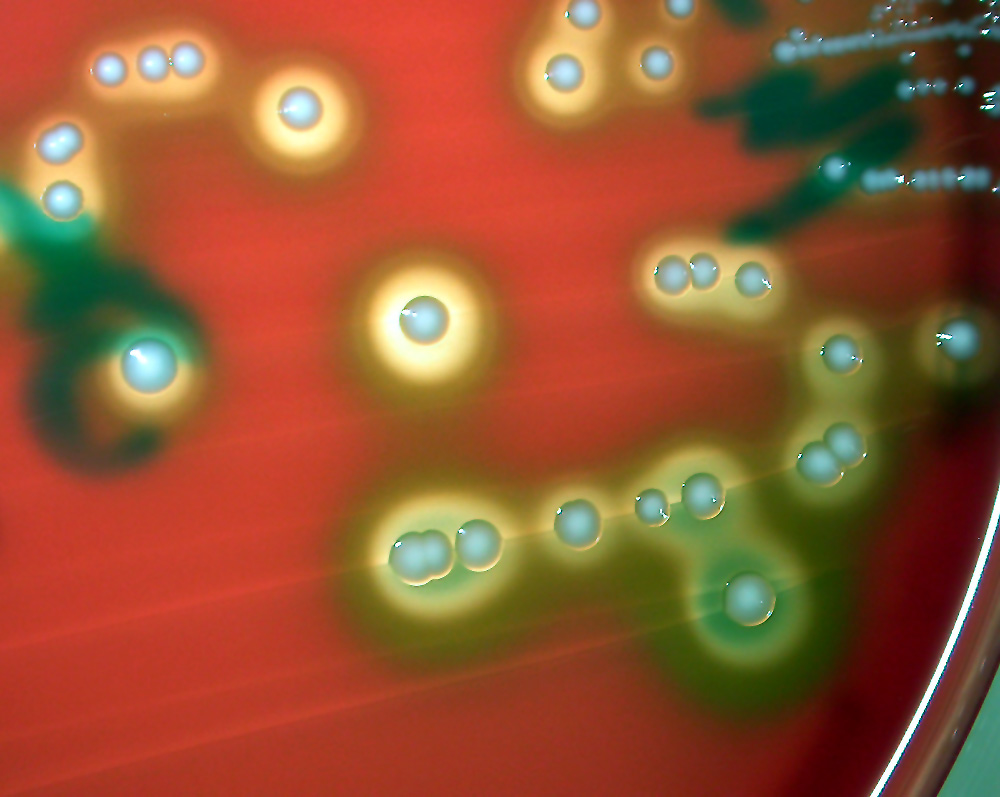
Aerococcus urinae
Aerococcus sind grampositive Kokken die bei älteren und immunschwachen Leuten Harnwegsinfekte verursachen können. Sie wachsen aerob und bauen nach einigen Tagen Schaferythrozyten ab, unter einer grösseren Vergrünung um die Kolonien. 
Schlüsselwörter: Aerococcus urinae

naturfotografie.ch
Willkommen beim Portal für Naturfotografen.
 |
Datei 1/6 |  |
 |
 |
 |
|
|||
|
| Diese Datei bewerten - derzeitige Bewertung : 1.7/5 mit 9 Stimme(n) | ||||||
|
||||||
| Datei-Information | |
| Dateiname: | Aerococcus_Urin3.jpg |
| Name des Albums: | Moritz Grubenmann / Mikrobiologie |
| Bewertung (9 Stimmen): |      |
| Schlüsselwörter: | Aerococcus / urinae |
| Dateigröße: | 149 KB |
| Hinzugefügt am: | 02. September 2004 |
| Abmessungen: | 1000 x 797 Pixel |
| Angezeigt: | 1825 mal |
| URL: | http://www.naturfotografie.ch/displayimage.php?pid=734 |
| Favoriten: | zu Favoriten hinzufügen |